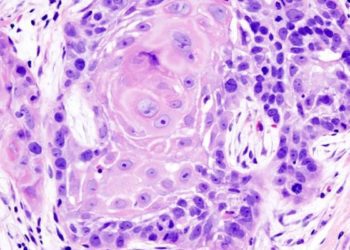

Image: Stanford
1. The prevalence of smoking has decreased in both men and women with the greatest decreases seen in younger individuals between the ages of 15-19.
2. Although the prevalence of smoking has decreased, the number of daily smokers has increased from 721 million to 967 million since 1980.
Evidence Rating Level: 2 (Good)
Study Rundown: Cigarette smoking is well known to be associated with an increased risk of heart disease, chronic obstructive pulmonary disease (COPD), and lung cancer. This study examined the worldwide changes in smoking prevalence from 1980 -2012. During these 22 years, the worldwide prevalence of tobacco smoking decreased to 31.1% from 41.2% in men and to 6.2% from 10.6% in women. The annual average decline was 0.9% in men and 1.7% in women with the largest decreases seen among 15-19 year olds. Although there was a decrease in the prevalence of smoking, there was an increase in the number of smokers. The prevalence of smoking did not correlate with the consumption or number smoked per day, highlighting that both need to be taken into account when monitoring smoking in a population. The strengths of this study include the large number of countries and participants included. However, this study is limited because either data could not be obtained fully in all countries or there are variations in the methods used to collect the data. Therefore, the true prevalence may be underestimated or overestimated and reporting bias may be present in data from certain countries.
Click to read the study, published today in JAMA
In-Depth [retrospective cohort]: This study determined the prevalence of tobacco use worldwide from 1980 to 2012. Since 1980, the prevalence of tobacco use has decreased from 41.2% to 31.1% (p <0.001) in men at a yearly decline of 0.9% (95% CI 0.8%-1.0%, p < 0.001) and 10.6% to 6.2% (P,0.001) in women at a decline of 1.7% (95% CI, 1.5% – 1.9%, p < 0.001). This decrease seems to happen in 3 phases with moderate declines from 1980 to 1996 (0.6%, 95% CI, 0.4%-0.8%), rapid declines from 1996 to 2006 (1.7%, 95% CI, 1.5% to 1.9%) and a slowdown in reductions from 2006 to 2012 (0.9%, 95% CI, 0.5% – 1.3%). Although the prevalence decreased, the number of men and women who smoked daily increased from 721 million in 1980 to 967 million (p < 0.001). Prevalence of daily smoking in men exceeded women in all countries except Sweden. The annual rate of change worldwide was not correlated to the prevalence of smokers in men (r = -0.26) or women (r =0.13). The number of cigarettes smoked per day also varied across countries and was not correlated to the prevalence of smokers.
By Camellia Banerjee and Brittany Hasty
More from this author: Increased risk of hospitalization following the release of inmates, Terminology used to describe ductal carcinoma in situ impacts patient preferences, Early onset dementia strongly correlated with alcohol intoxication in men, Perceived futility of treatments in the ICU dependent on key patient factors, GM-CSF therapy may have benefits for patients with peripheral artery disease
© 2012-2014 2minutemedicine.com. All rights reserved. No works may be reproduced without expressed written consent from 2minutemedicine.com. Disclaimer: We present factual information directly from peer reviewed medical journals. No post should be construed as medical advice and is not intended as such by the authors, editors, staff or by 2minutemedicine.com. PLEASE SEE A HEALTHCARE PROVIDER IN YOUR AREA IF YOU SEEK MEDICAL ADVICE OF ANY SORT.